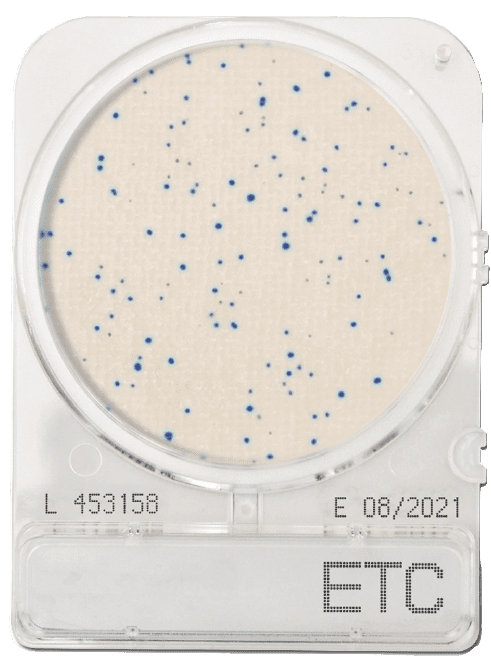

CompactDry ETC
Enterococci are abundant in the gastrointestinal tract of humans and animals and can be used as an index of good hygiene and sanitation.
Most Enterococcus species are regarded as “low-grade” pathogens, however, some Enterococci are opportunistic and responsible for septicaemia, urinary tract infections, and abdominal infections. Two of the main pathogenic species are Enterococcus faecalis and Enterococcus faecium.